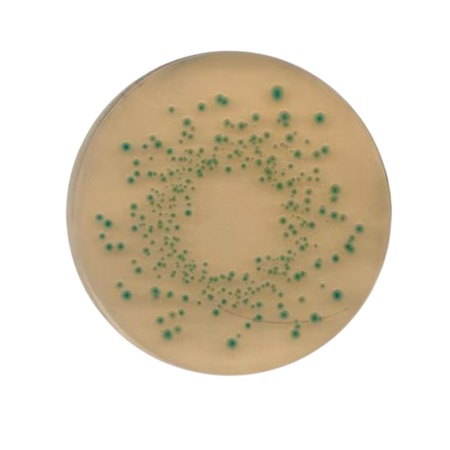
product

Dehydrated Perfringens Agar Base for selective and differential cultivation of Clostridium spp. in food, beverage and environmental microbiological testing; supplied under the NutriSelect Plus brand.
Perfringens Agar Base, catalogue No. 39727, is a dehydrated granular culture medium supplied by MilliporeSigma / Merck under the NutriSelect® Plus designation. This medium is formulated to support selective and differential cultivation of Clostridium species, particularly Clostridium perfringens, in microbiological quality control testing. The powder contains nutrients and selective components that favour growth of target organisms while restricting competing microbial flora. It is widely used in food, beverage, cosmetic, personal care and environmental laboratory workflows for bioburden assessment and microbial analysis.
Advantages
- Selective and differential medium for Clostridium spp. cultivation.
- NutriSelect® Plus quality ensures consistent performance in microbiological assays.
- Supports routine quality control testing in diverse laboratory settings.
- Powdered dehydrated form allows flexible preparation of agar plates or broths.
- Suitable for food, beverage, cosmetic and environmental microbiology workflows.
Technical specifications
| Product name | Perfringens Agar Base |
| Catalogue number | 39727 |
| Brand / quality | NutriSelect® Plus |
| Form | Dehydrated powder |
| Technique | Microbiological culture / selective differentiation |
| Suitable for | *Clostridium* spp., including *C. perfringens* |
| Typical use | Food, beverage, cosmetic, personal care, environmental microbiology |
| Nutrient components (typical) | Agar, beef extract, ferric ammonium citrate, papaic digest of soybean meal, sodium metabisulphite, tryptose, yeast extract |
| Formulation | Powder for medium preparation |
| Storage conditions | 15–25 °C, dry |
| Brand | Merck |
| Pack size | 500 g |